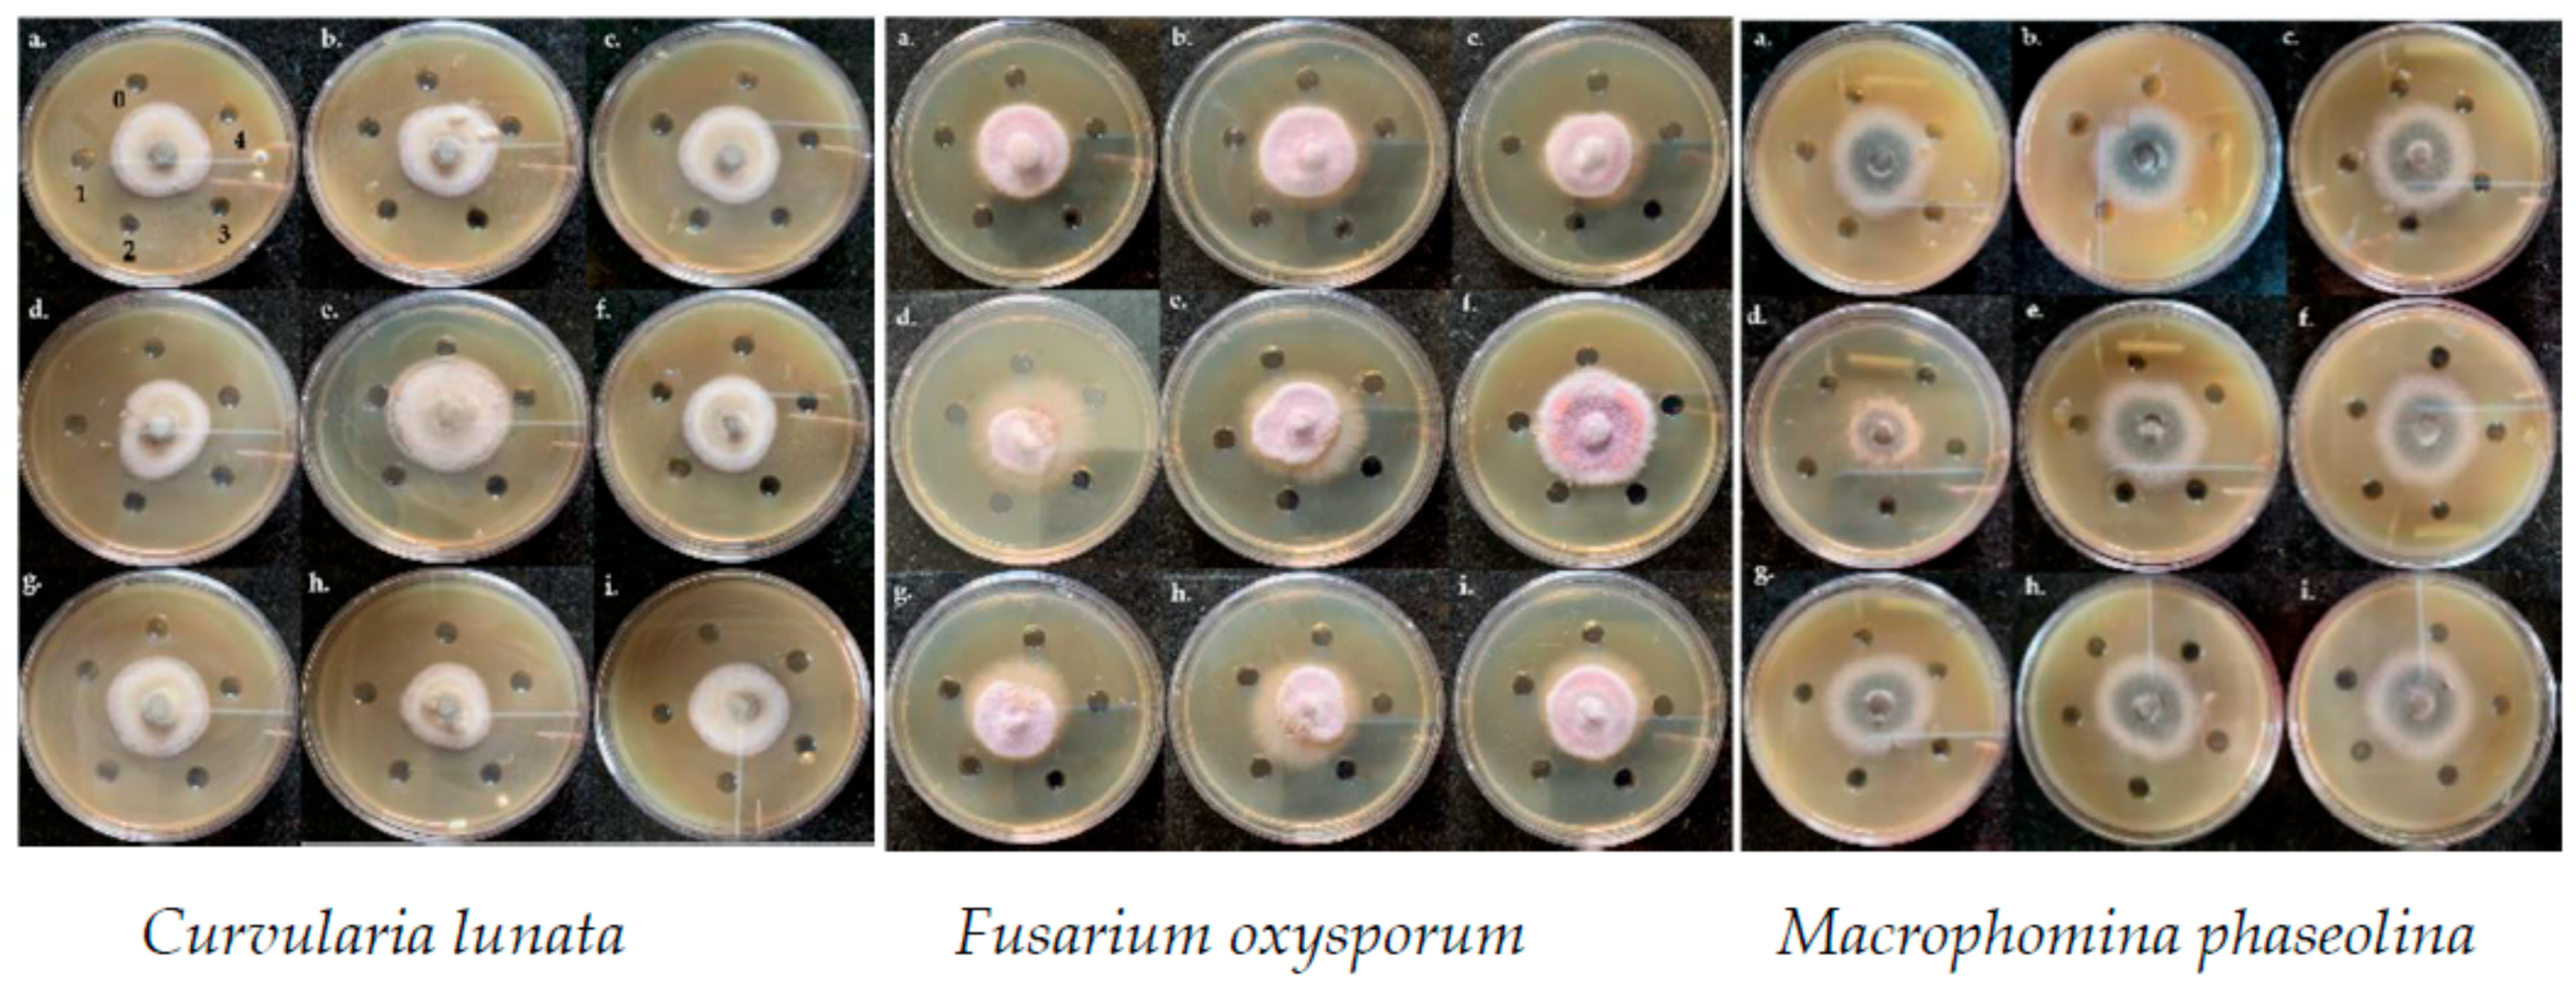
Jof 07 00223 g007 Jof 07 00223 g007

Differential Antimycotic and Antioxidant Potentials of Chemically Synthesized Zinc-Based Nanoparticles Derived from Different Reducing/Complexing Agents against Pathogenic Fungi of Maize Crop
Abstract
1. Introduction
2. Materials and Methods
2.1. Chemicals and Microbial Cultures
2.2. Synthesis and Characterization of NMs
2.2.1. UV-Vis Spectroscopy
2.2.2. Transmission Electron Microscopy
2.2.3. X-ray Diffraction Spectroscopy
2.2.4. Fourier Transform Infra-Red Spectroscopy
2.3. Anti-Oxidant Activity of the ZnNMs
2.4. Anti-Mycotic Activity of the ZnNPs
2.4.1. Agar Well Diffusion Assay
2.4.2. Optical Research Microscopy Studies of the Fungal Hyphae
2.5. Fungal Genomic DNA Degrading Potential of the ZnNPs
2.6. Statistical Analyses
3. Results
3.1. Characterization of ZnNPs
3.1.1. UV-Visible Spectroscopy
3.1.2. Transmission Electron Microscopy
3.1.3. X-ray Diffraction Spectroscopy
3.1.4. Fourier Transform Infra-Red Spectroscopy
3.2. Anti-Oxidant Activity of the ZnNPs
3.3. Anti-Mycotic Activity of the ZnNPs
3.3.1. Agar Well Diffusion Assay
3.3.2. Optical Research Microscopy Studies of the Fungal Hyphae
3.4. Fungal Genomic DNA Degrading Potential of the ZnNPs
4. Discussion
5. Conclusions
Author Contributions
Funding
Institutional Review Board Statement
Informed Consent Statement
Data Availability Statement
Acknowledgments
Conflicts of Interest
References
- Fones, H.N.; Bebber, D.P.; Chaloner, T.M.; Kay, W.T.; Steinberg, G.; Gurr, S.J. Threats to global food security from emerging fungal and oomycete crop pathogens. Nat. Food 2020, 1, 332–342. [Google Scholar] [CrossRef]
- Chaloner, T.M.; Gurr, S.J.; Bebber, D.P. The global burden of plant disease tracks crop yields under climate change. bioRxiv 2020. [Google Scholar] [CrossRef]
- Elad, Y.; Pertot, I. Climate Change Impacts on Plant Pathogens and Plant Diseases. J. Crop Improv. 2014, 28, 99–139. [Google Scholar] [CrossRef]
- Ruffo, M.L.; Gentry, L.F.; Henninger, A.S.; Seebauer, J.R.; Below, F.E. Evaluating management factor contributions to reduce corn yield gaps. Agron. J. 2015, 107, 495–505. [Google Scholar] [CrossRef]
- Mueller, D.S.; Pathology, P.; Wise, K.A.; Bosley, D.B.; State, C.; Collins, F.; Bradley, C.A.; Pathology, P. Corn Yield Loss Estimates Due to Diseases in the United States and Ontario, Canada from 2012 to 2015. Plant Health Prog. 2016, 17, 211–222. [Google Scholar] [CrossRef]
- Bedford, D.; Claro, J.; Giusti, A.M.; Karumathy, G.; Lucarelli, L.; Mancini, D.; Marocco, E.; Milo, M.; Yang, D. Food Outlook; FAO: Rome, Itlay, 2018; ISBN 978-92-5-109782-3. [Google Scholar]
- Kalia, A.; Abd-Elsalam, K.A.; Kuca, K. Zinc-based nanomaterials for diagnosis and management of plant diseases: Ecological safety and future prospects. J. Fungi 2020, 6, 222. [Google Scholar] [CrossRef] [PubMed]
- Kalia, A.; Kaur, J.; Kaur, A.; Singh, N. Antimycotic activity of biogenically synthesised metal and metal oxide nanoparticles against plant pathogenic fungus Fusarium moniliforme (F. fujikuroi). Indian J. Exp. Biol. 2020, 58, 263–270. [Google Scholar]
- Jesmin, R.; Chanda, A. Restricting mycotoxins without killing the producers: A new paradigm in nano-fungal interactions. Appl. Microbiol. Biotechnol. 2020, 104, 2803–2813. [Google Scholar] [CrossRef] [PubMed]
- Hassan, M.; Zayton, M.A.; El-feky, S.A. Role of Green Synthesized Zno Nanoparticles as Antifungal against Post-Harvest Gray and Black Mold of Sweet Bell. J. Biotechnol. Bioeng. 2019, 3, 8–15. [Google Scholar]
- He, L.; Liu, Y.; Mustapha, A.; Lin, M. Antifungal activity of zinc oxide nanoparticles against Botrytis cinerea and Penicillium expansum. Microbiol. Res. 2011, 166, 207–215. [Google Scholar] [CrossRef] [PubMed]
- Abdelhakim, H.K.; El-Sayed, E.R.; Rashidi, F.B. Biosynthesis of zinc oxide nanoparticles with antimicrobial, anticancer, antioxidant and photocatalytic activities by the endophytic Alternaria tenuissima. J. Appl. Microbiol. 2020, 128, 1634–1646. [Google Scholar] [CrossRef]
- Al-Dhabaan, F.A.; Shoala, T.; Ali, A.A.; Alaa, M.; Abd-Elsalam, K.; Abd-, K. Chemically-Produced Copper, Zinc Nanoparticles and Chitosan-Bimetallic Nanocomposites and Their Antifungal Activity against Three Phytopathogenic Fungi. Int. J. Agric. Technol. 2017, 13, 753–769. [Google Scholar]
- Hernández-Meléndez, D.; Salas-Téllez, E.; Zavala-Franco, A.; Téllez, G.; Méndez-Albores, A.; Vázquez-Durán, A. Inhibitory effect of flower-shaped zinc oxide nanostructures on the growth and aflatoxin production of a highly toxigenic strain of Aspergillus flavus Link. Materials 2018, 11, 1265. [Google Scholar] [CrossRef] [PubMed]
- Kairyte, K.; Kadys, A.; Luksiene, Z. Antibacterial and antifungal activity of photoactivated ZnO nanoparticles in suspension. J. Photochem. Photobiol. B Biol. 2013, 128, 78–84. [Google Scholar] [CrossRef] [PubMed]
- Karimiyan, A.; Najafzadeh, H.; Ghorbanpour, M.; Hekmati-Moghaddam, S.H. Antifungal Effect of Magnesium Oxide, Zinc Oxide, Silicon Oxide and Copper Oxide Nanoparticles Against Candida albicans. Zahedan J. Res. Med. Sci. 2015, 17, 2–4. [Google Scholar] [CrossRef]
- Dimkpa, C.O.; McLean, J.E.; Britt, D.W.; Anderson, A.J. Antifungal activity of ZnO nanoparticles and their interactive effect with a biocontrol bacterium on growth antagonism of the plant pathogen Fusarium graminearum. BioMetals 2013, 26, 913–924. [Google Scholar] [CrossRef]
- Dos Santos, R.A.A.; D’Addazio, V.; Silva, J.V.G.; Falqueto, A.R.; Barreto da Silva, M.; Schmildt, E.R.; Fernandes, A.A. Antifungal Activity of Copper, Zinc and Potassium Compounds on Mycelial Growth and Conidial Germination of Fusarium solani f. sp. piperis. Microbiol. Res. J. Int. 2019, 29, 1–11. [Google Scholar] [CrossRef]
- Savi, G.D.; Bortoluzzi, A.J.; Scussel, V.M. Antifungal properties of Zinc-compounds against toxigenic fungi and mycotoxin. Int. J. Food Sci. Technol. 2013, 48, 1834–1840. [Google Scholar] [CrossRef]
- Helaly, M.N.; El-Metwally, M.A.; El-Hoseiny, H.; Omar, S.A.; El-Sheery, N.I. Effect of nanoparticles on biological contamination of in vitro cultures and organogenic regeneration of banana. Aust. J. Crop Sci. 2014, 8, 612–624. [Google Scholar]
- Yehia, R.; Ahmed, O.F. In Vitro study of the antifungal efficacy of zinc oxide nanoparticles against Fusarium oxysporum and Penicilium expansum. Afr. J. Microbiol. Res. 2013, 7, 1917–1923. [Google Scholar] [CrossRef]
- Sardella, D.; Gatt, R.; Valdramidis, V.P. Assessing the efficacy of zinc oxide nanoparticles against Penicillium expansum by automated turbidimetric analysis. Mycology 2018, 9, 43–48. [Google Scholar] [CrossRef]
- Zabrieski, Z.; Morrell, E.; Hortin, J.; Dimkpa, C.; McLean, J.; Britt, D.; Anderson, A. Pesticidal activity of metal oxide nanoparticles on plant pathogenic isolates of Pythium. Ecotoxicology 2015, 24, 1305–1314. [Google Scholar] [CrossRef] [PubMed]
- Decelis, S.; Sardella, D.; Triganza, T.; Brincat, J.P.; Gatt, R.; Valdramidis, V.P. Assessing the anti-fungal efficiency of filters coated with zinc oxide nanoparticles. R. Soc. Open Sci. 2017, 4, 1–9. [Google Scholar] [CrossRef] [PubMed]
- Davis, D.; Singh, S. ZnO Nanoparticles Synthesis by Sol-Gel Method and Characterization. Indian J. Nanosci. 2016, 4, 1–4. [Google Scholar]
- Wahab, R.; Ansari, S.G.; Kim, Y.S.; Dhage, M.S.; Seo, H.K.; Song, M.; Shin, H.S. Effect of annealing on the conversion of zns to zno nanoparticles synthesized by the sol-gel method using zinc acetate and thiourea. Met. Mater. Int. 2009, 15, 453–458. [Google Scholar] [CrossRef]
- Ma, J.; Zhu, W.; Tian, Y.; Wang, Z. Preparation of Zinc Oxide-Starch Nanocomposite and Its Application on Coating. Nanoscale Res. Lett. 2016, 11. [Google Scholar] [CrossRef]
- Raliya, R.; Avery, C.; Chakrabarti, S.; Biswas, P. Photocatalytic degradation of methyl orange dye by pristine titanium dioxide, zinc oxide, and graphene oxide nanostructures and their composites under visible light irradiation. Appl. Nanosci. 2017, 7, 253–259. [Google Scholar] [CrossRef]
- Ma, J.; Sun, Z.; Wang, Z.; Zhou, X. Preparation of ZnO–cellulose nanocomposites by different cellulose solution systems with a colloid mill. Cellulose 2016, 23, 3703–3715. [Google Scholar] [CrossRef]
- Chen, Z.; Shuai, L.; Zheng, B.; Wu, D. Synthesis of zinc oxide nanoparticles with good photocatalytic activities under stabilization of bovine serum albumin. J. Wuhan Univ. Technol. Mater. Sci. Ed. 2017, 32, 1061–1066. [Google Scholar] [CrossRef]
- Kalia, A.; Manchanda, P.; Bhardwaj, S.; Singh, G. Biosynthesized silver nanoparticles from aqueous extracts of sweet lime fruit and callus tissues possess variable antioxidant and antimicrobial potentials. Inorg. Nano-Met. Chem. 2020, 50, 1053–1062. [Google Scholar] [CrossRef]
- Azizi, S.; Mohamad, R.; Shahri, M.M.; McPhee, D.J. Green microwave-assisted combustion synthesis of zinc oxide nanoparticles with Citrullus colocynthis (L.) schrad: Characterization and biomedical applications. Molecules 2017, 22, 301. [Google Scholar] [CrossRef]
- Magaldi, S.; Mata-Essayag, S.; De Capriles, C.H.; Perez, C.; Colella, M.T.; Olaizola, C.; Ontiveros, Y. Well diffusion for antifungal susceptibility testing. Int. J. Infect. Dis. 2004, 8, 39–45. [Google Scholar] [CrossRef]
- Moslem, M.; Abd-Elsalam, K.; Yassin, M.; Bahkali, A. First morphomolecular identification of penicillium griseofulvum and penicillium aurantiogriseum toxicogenic isolates associated with blue mold on apple. Foodborne Pathog. Dis. 2010, 7, 857–861. [Google Scholar] [CrossRef]
- Rajesh, R.W.; Jaya, L.R.; Niranjan, K.S.; Vijay, D.M.; Sahebrao, B.K. Phytosynthesis of silver nanoparticle using Gliricidia sepium (Jacq.). Curr. Nanosci. 2009, 5, 117–122. [Google Scholar]
- Yan, J.K.; Wang, Y.Y.; Zhu, L.; Wu, J.Y. Green synthesis and characterization of zinc oxide nanoparticles using carboxylic curdlan and their interaction with bovine serum albumin. RSC Adv. 2016, 6, 77752–77759. [Google Scholar] [CrossRef]
- Kumar, H.; Rani, R. Structural and Optical Characterization of ZnO Nanoparticles Synthesized by Microemulsion Route. Int. Lett. Chem. Phys. Astron. 2013, 19, 26–36. [Google Scholar] [CrossRef]
- Rajiv, P.; Rajeshwari, S.; Venckatesh, R. Bio-Fabrication of zinc oxide nanoparticles using leaf extract of Parthenium hysterophorus L. and its size-dependent antifungal activity against plant fungal pathogens. Spectrochim. Acta Part A Mol. Biomol. Spectrosc. 2013, 112, 384–387. [Google Scholar] [CrossRef]
- Kayani, Z.N.; Saleemi, F.; Batool, I. Synthesis and Characterization of ZnO Nanoparticles. Mater. Today Proc. 2015, 2, 5619–5621. [Google Scholar] [CrossRef]
- Ambika, S.; Sundrarajan, M. Green biosynthesis of ZnO nanoparticles using Vitex negundo L. extract: Spectroscopic investigation of interaction between ZnO nanoparticles and human serum albumin. J. Photochem. Photobiol. B Biol. 2015, 149, 143–148. [Google Scholar] [CrossRef] [PubMed]
- Zamiri, R.; Zakaria, A.; Ahangar, H.A.; Darroudi, M.; Zak, A.K.; Drummen, G.P.C. Aqueous starch as a stabilizer in zinc oxide nanoparticle synthesis via laser ablation. J. Alloys Compd. 2012, 516, 41–48. [Google Scholar] [CrossRef]
- Panchakarla, L.S.; Govindaraj, A.; Rao, C.N.R. Formation of ZnO nanoparticles by the reaction of zinc metal with aliphatic alcohols. J. Clust. Sci. 2007, 18, 660–670. [Google Scholar] [CrossRef]
- Talam, S.; Karumuri, S.R.; Gunnam, N. Synthesis, Characterization, and Spectroscopic Properties of ZnO Nanoparticles. ISRN Nanotechnol. 2012, 2012, 1–6. [Google Scholar] [CrossRef]
- Yoshikawa, H.; Adachi, S. Optical constants of ZnO. Jpn. J. Appl. Phys. 1997, 36, 6237–6243. [Google Scholar] [CrossRef]
- Joseph, D.P.; Venkateswaran, C. Bandgap Engineering in ZnO By Doping with 3d Transition Metal Ions. J. At. Mol. Opt. Phys. 2011, 2011, 1–7. [Google Scholar] [CrossRef]
- Feng, X.; Wang, Z.; Zhang, C.; Wang, P. Electronic structure and energy band of IIIA doped group ZnO nanosheets. J. Nanomater. 2013, 2013, 181979. [Google Scholar] [CrossRef]
- Zakirov, M.I.; Semen’ko, M.P.; Korotchenkov, O.A. A simple sonochemical synthesis of nanosized ZnO from zinc acetate and sodium hydroxide. J. Nano-Electron. Phys. 2018, 10, 4–7. [Google Scholar] [CrossRef]
- Stan, M.; Popa, A.; Toloman, D.; Silipas, T.D.; Vodnar, D.C. Antibacterial and antioxidant activities of ZnO nanoparticles synthesized using extracts of Allium sativum, Rosmarinus officinalis and Ocimum basilicum. Acta Metall. Sin. Engl. Lett. 2016. [Google Scholar] [CrossRef]
- Yakimovich, N.O.; Ezhevskii, A.A.; Guseinov, D.V.; Smirnova, L.A.; Gracheva, T.A.; Klychkov, K.S. Antioxidant properties of gold nanoparticles studied by ESR spectroscopy. Russ. Chem. Bull. 2008, 57, 520–523. [Google Scholar] [CrossRef]
- Watanabe, A.; Kajita, M.; Kim, J.; Kanayama, A.; Takahashi, K.; Mashino, T.; Miyamoto, Y. In Vitro free radical scavenging activity of platinum nanoparticles. Nanotechnology 2009, 20. [Google Scholar] [CrossRef]
- Dipankar, C.; Murugan, S. The green synthesis, characterization and evaluation of the biological activities of silver nanoparticles synthesized from Iresine herbstii leaf aqueous extracts. Colloids Surf. B Biointerfaces 2012, 98, 112–119. [Google Scholar] [CrossRef]
- Ali, A.; Ambreen, S.; Maqbool, Q.; Naz, S.; Shams, M.F.; Ahmad, M.; Phull, A.R.; Zia, M. Zinc impregnated cellulose nanocomposites: Synthesis, characterization and applications. J. Phys. Chem. Solids 2016, 98, 174–182. [Google Scholar] [CrossRef]
- Arciniegas-Grijalba, P.A.; Patiño-Portela, M.C.; Mosquera-Sánchez, L.P.; Guerrero-Vargas, J.A.; Rodríguez-Páez, J.E. ZnO nanoparticles (ZnO-NPs) and their antifungal activity against coffee fungus Erythricium salmonicolor. Appl. Nanosci. 2017, 7, 225–241. [Google Scholar] [CrossRef]
- Singh, S.; Kuca, K.; Kalia, A. Alterations in Growth and Morphology of Ganoderma lucidum and Volvariella volvaceae in Response to Nanoparticle Supplementation. Mycobiology 2020, 48, 383–391. [Google Scholar] [CrossRef] [PubMed]
- Samanta, A.; Medintz, I.L. Nanoparticles and DNA-a powerful and growing functional combination in bionanotechnology. Nanoscale 2016, 8, 9037–9095. [Google Scholar] [CrossRef]
- Hashim, A.F.; Youssef, K. Ecofriendly nanomaterials for controlling gray mold of table grapes and maintaining postharvest quality. Eur. J. Plant Pathol. 2019, 377–388. [Google Scholar] [CrossRef]
- Alghuthaymi, M.A.; Abd-Elsalam, K.A.; Shami, A.; Said-Galive, E.; Shtykova, E.V.; Naumkin, A.V. Silver/chitosan nanocomposites: Preparation and characterization and their fungicidal activity against dairy cattle toxicosis Penicillium expansum. J. Fungi 2020, 6, 51. [Google Scholar] [CrossRef] [PubMed]
- Abd-Elsalam, K.A.; Alghuthaymi, M.A.; Shami, A.; Rubina, M.S.; Abramchuk, S.S.; Shtykova, E.V.; Vasil’kov, A.Y. Copper-chitosan nanocomposite hydrogels against aflatoxigenic Aspergillus flavus from dairy cattle feed. J. Fungi 2020, 6, 112. [Google Scholar] [CrossRef] [PubMed]
- Das, B.; Khan, M.I.; Jayabalan, R.; Behera, S.K.; Yun, S.-I.; Tripathy, S.K.; Mishra, A. Understanding the Antifungal Mechanism of Ag@ZnO Core-shell Nanocomposites against Candida krusei. Sci. Rep. 2016, 6, 1–12. [Google Scholar] [CrossRef] [PubMed]
- Saha, S.; Sarkar, P. Understanding the interaction of DNA-RNA nucleobases with different ZnO nanomaterials. Phys. Chem. Chem. Phys. 2014, 16, 15355–15366. [Google Scholar] [CrossRef] [PubMed]
- Das, S.; Chatterjee, S.; Pramanik, S.; Devi, P.S.; Kumar, G.S. A new insight into the interaction of ZnO with calf thymus DNA through surface defects. J. Photochem. Photobiol. B Biol. 2018, 178, 339–347. [Google Scholar] [CrossRef]
- Nadhman, A.; Sirajuddin, M.; Nazir, S.; Yasinzai, M. Photo-induced Leishmania DNA degradation by silver-doped zinc oxide nanoparticle: An in-vitro approach. IET Nanobiotechnol. 2016, 10, 129–133. [Google Scholar] [CrossRef] [PubMed]

Publisher’s Note: MDPI stays neutral with regard to jurisdictional claims in published maps and institutional affiliations. |
© 2021 by the authors. Licensee MDPI, Basel, Switzerland. This article is an open access article distributed under the terms and conditions of the Creative Commons Attribution (CC BY) license (http://creativecommons.org/licenses/by/4.0/).
Share and Cite
Kalia, A.; Kaur, J.; Tondey, M.; Manchanda, P.; Bindra, P.; Alghuthaymi, M.A.; Shami, A.; Abd-Elsalam, K.A. Differential Antimycotic and Antioxidant Potentials of Chemically Synthesized Zinc-Based Nanoparticles Derived from Different Reducing/Complexing Agents against Pathogenic Fungi of Maize Crop. J. Fungi 2021, 7, 223. https://doi.org/10.3390/jof7030223
Kalia A, Kaur J, Tondey M, Manchanda P, Bindra P, Alghuthaymi MA, Shami A, Abd-Elsalam KA. Differential Antimycotic and Antioxidant Potentials of Chemically Synthesized Zinc-Based Nanoparticles Derived from Different Reducing/Complexing Agents against Pathogenic Fungi of Maize Crop. Journal of Fungi. 2021; 7(3):223. https://doi.org/10.3390/jof7030223
Chicago/Turabian StyleKalia, Anu, Jashanpreet Kaur, Manisha Tondey, Pooja Manchanda, Pulkit Bindra, Mousa A. Alghuthaymi, Ashwag Shami, and Kamel A. Abd-Elsalam. 2021. "Differential Antimycotic and Antioxidant Potentials of Chemically Synthesized Zinc-Based Nanoparticles Derived from Different Reducing/Complexing Agents against Pathogenic Fungi of Maize Crop" Journal of Fungi 7, no. 3: 223. https://doi.org/10.3390/jof7030223
APA StyleKalia, A., Kaur, J., Tondey, M., Manchanda, P., Bindra, P., Alghuthaymi, M. A., Shami, A., & Abd-Elsalam, K. A. (2021). Differential Antimycotic and Antioxidant Potentials of Chemically Synthesized Zinc-Based Nanoparticles Derived from Different Reducing/Complexing Agents against Pathogenic Fungi of Maize Crop. Journal of Fungi, 7(3), 223. https://doi.org/10.3390/jof7030223

